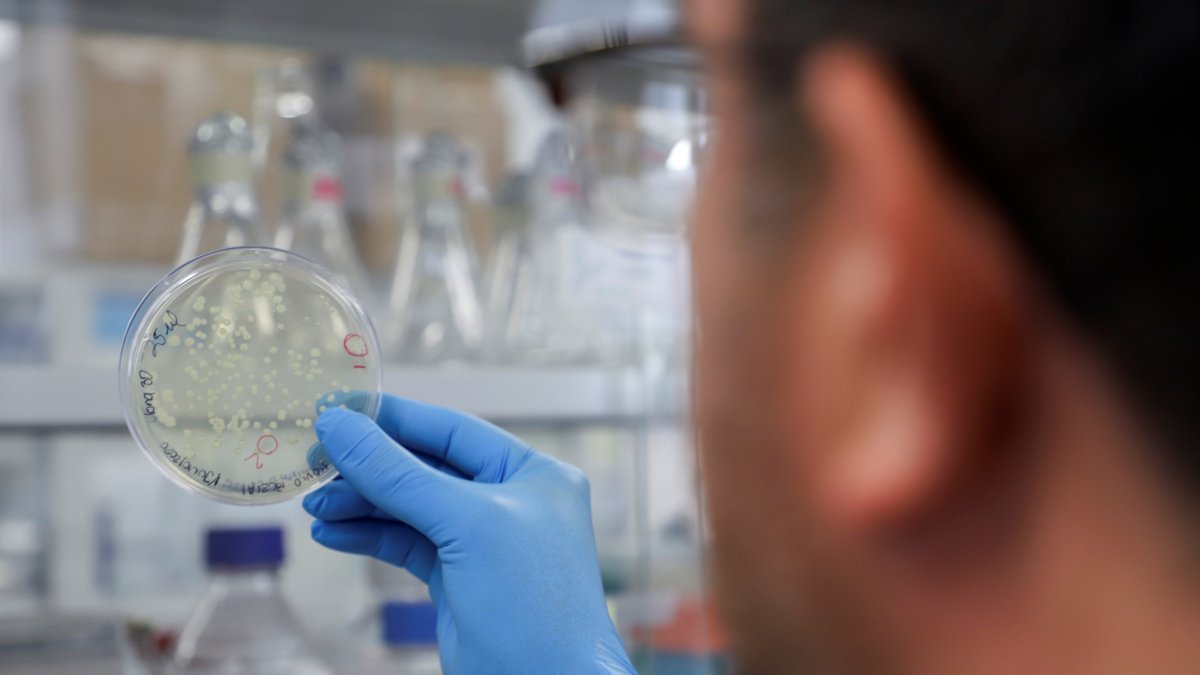
Investigadores descubren una posible nueva variante de la covid-19 en Bélgica.

Científicos descubren una posible nueva variante de la covid-19 en Bélgica
Los efectos de la nueva variante aún se desconocen, según informó este lunes el diario belga Le Soir
Investigadores descubren una posible nueva variante de la covid-19 en Bélgica.
Investigadores de la Universidad de Lieja descubrieron el pasado enero una nueva mutación del virus Sars-Cov-2, responsable de la covid-19, cuyos efectos aún se desconocen, según informó este lunes el diario belga Le Soir.
Ciencia y Tecnología
La variante británica se asocia con un 61 % más de riesgo de muerte
Gilson Pinargote
La nueva mutación, conocida como Spike Insertion (SI) y cuyo nombre científico es B.1.214, no está clasificada aún como "variante preocupante" (VOC), como sí lo están la llamada variante británica (B.1.117), la variante sudafricana (B.1.351) y la variante brasileña (P.1).
Al contrario que dichas variantes, la mutación descubierta en Bélgica se ha producido a través de la inserción de nueve nucléotidos a la secuencia de la proteína del virus, mientras que las anteriores se crearon por supresiones en el genoma, según explicó a Le Soir Vicent Bours, responsable del laboratorio de análisis y secuenciación del virus Sars-Cov-2 en la Universidad de Lieja.
Sin embargo, los investigadores subrayaron que esta nueva variante "aún no suscita ninguna preocupación especial sobre su peligrosidad" y que no se sabe si ofrece alguna ventaja al virus original en términos de transmisibilidad.
Internacional
204 casos con variantes brasileña y británica de la covid identificadas en Brasil
Vanessa López
Esta posible variante representa ya el 4 % de los contagios de las muestras observadas, más o menos lo mismo que las variantes sudafricana y brasileña, mientras que la británica constituye en este momento entre el 70 y el 75 % de los contagios en Bélgica, según los investigadores.
No obstante, "podemos ver que está aumentando progresivamente en Bélgica, sobre todo en Bruselas, el Brabante Flamenco y Henao, pero estamos casi seguros de que no es una cepa belga", explicó Bours, que comentó que esta variación "podría proceder del África subsahariana y se habría implantado en nosotros a través de los viajes".